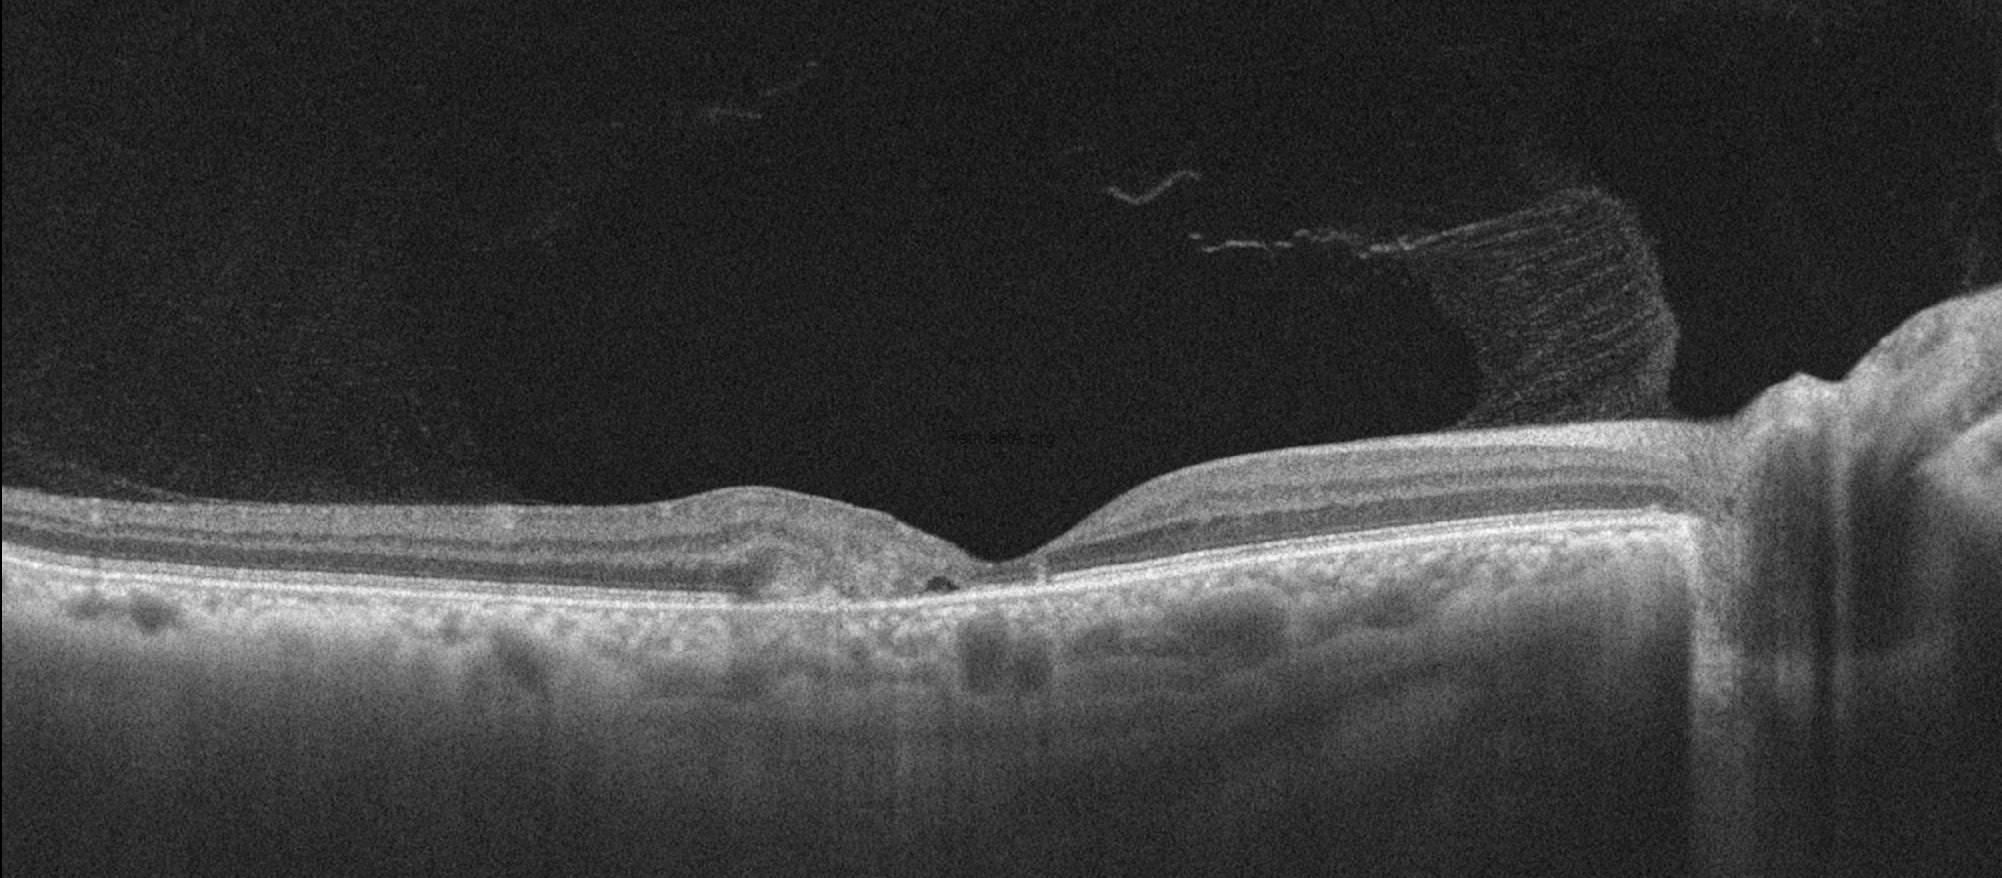
1
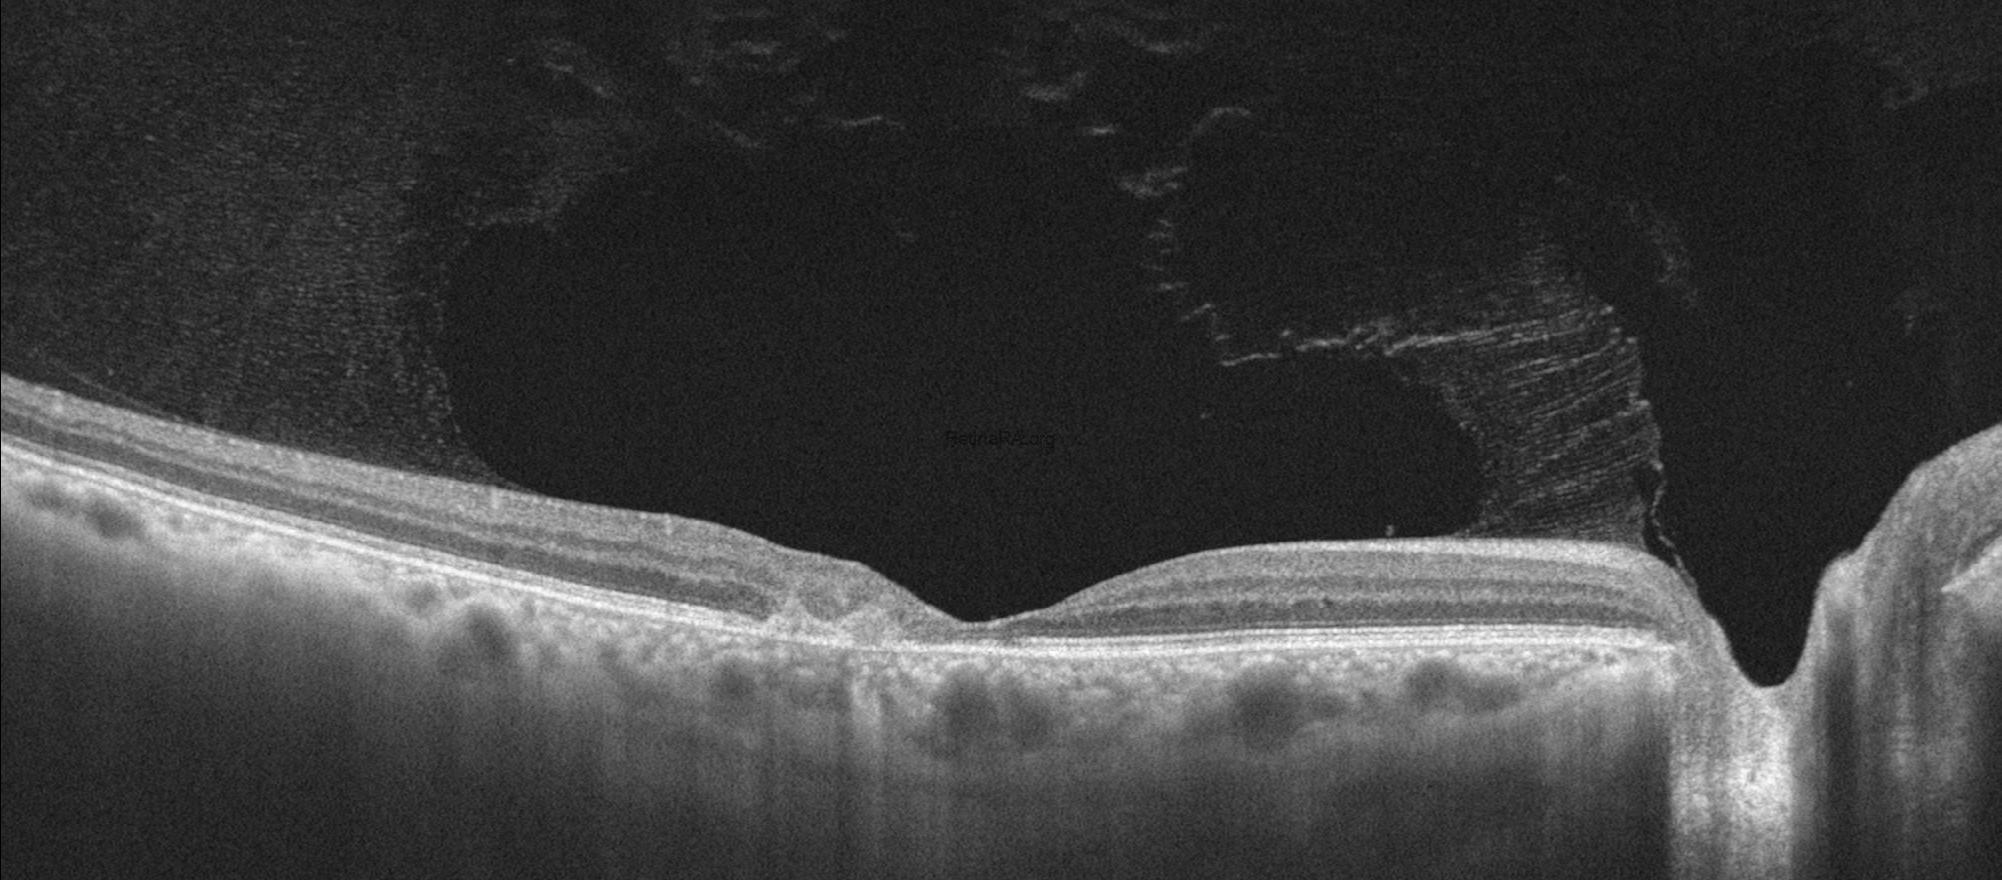
3
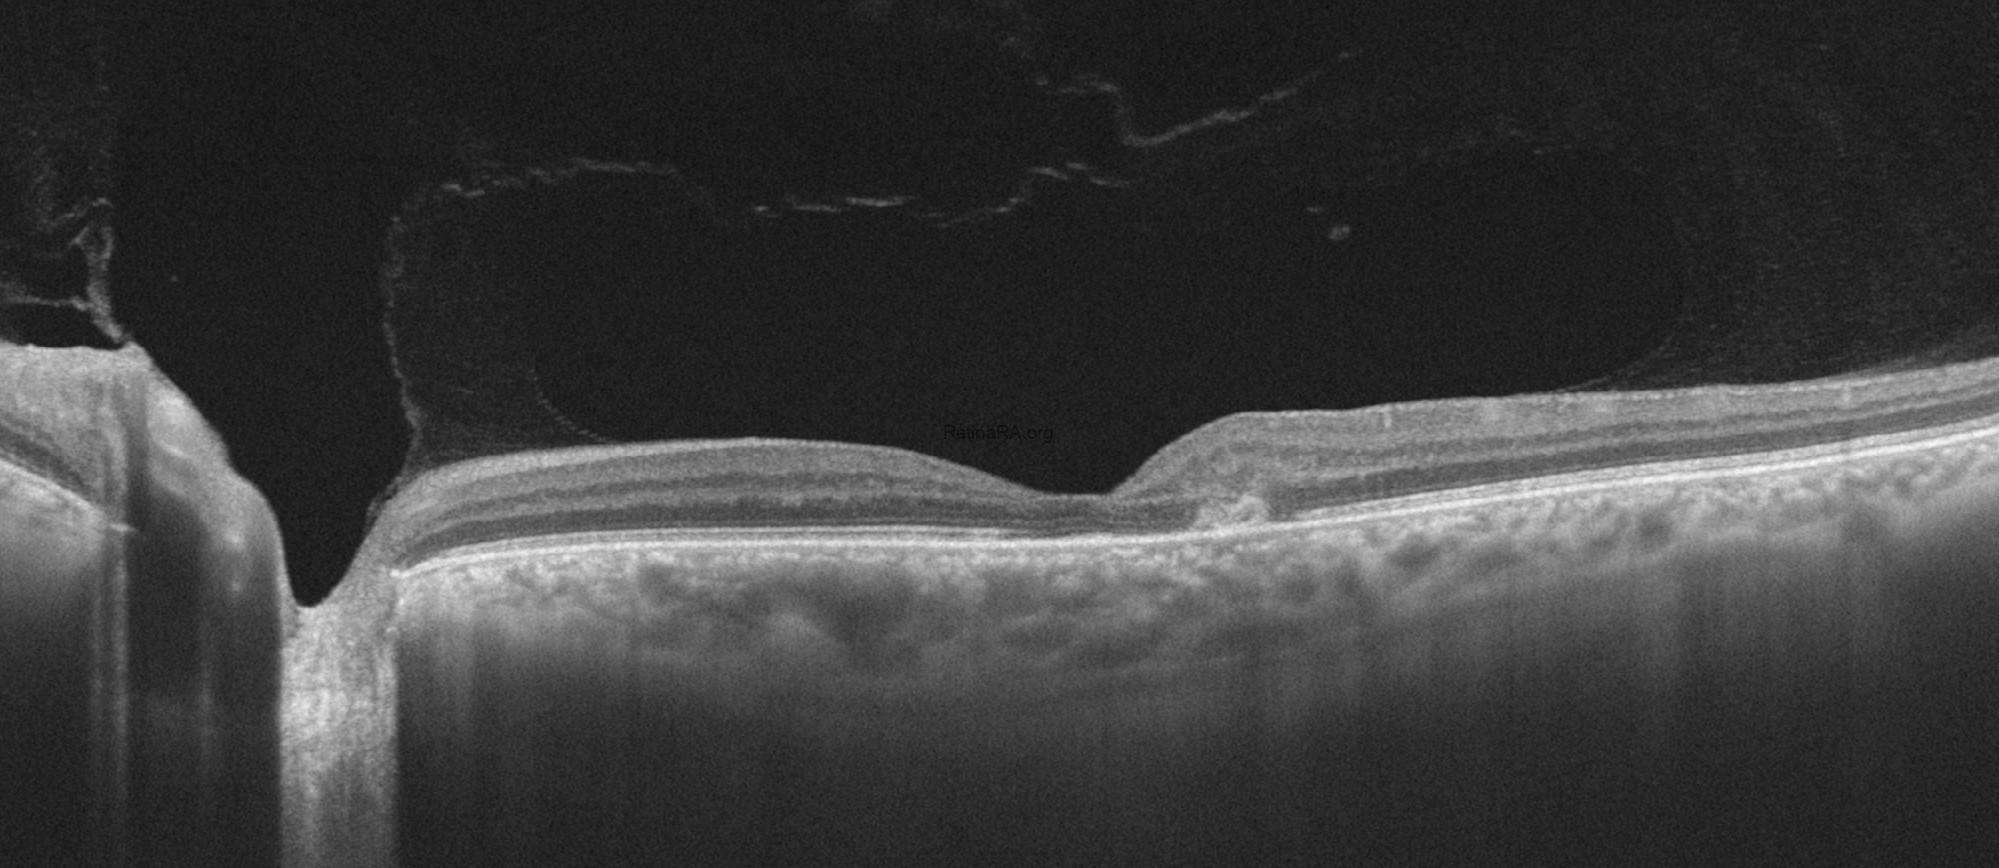
4

A 58-year-old male patient presented to our clinic with a complaint of decreased vision. On initial examination, best-corrected visual acuity was 0.2 in the right eye and 0.05 in the left eye. Intraocular pressure was measured as 20 mmHg in both eyes, and the anterior segment examination was unremarkable. Fundus examination revealed bilateral parafoveal retinal transparency loss with right-angle venules and telangiectatic vessels, predominantly involving the temporal macula.


Color fundus photography demonstrated pigmentary alterations temporal to the fovea, along with ectatic capillaries and whitish crystalline deposits. Both eyes showed parafoveal loss of retinal transparency with right-angled venules and telangiectatic vessels, more prominent in the temporal macula. Henle fiber layer hemorrhage appeared in the left eye.

Fundus autofluorescence imaging demonstrated increased parafoveal autofluorescence, most prominently involving the temporal macula, reflecting loss of macular pigment and underlying Müller cell dysfunction. This hyperautofluorescent pattern may become irregular or patchy. Areas corresponding to choroidal neovascularization, subretinal hemorrhage, fibrosis, or retinal pigment epithelium damage appear as focal zones of reduced autofluorescence.

Optical coherence tomography (OCT) demonstrated characteristic parafoveal structural alterations, choroidal neovascularization in both eyes, and Henle fiber layer hemorrhage in the left eye. Early findings include inner and outer retinal cavitations, particularly involving the inner nuclear and outer plexiform layers, often without significant retinal thickening. Disruption and attenuation of the ellipsoid zone are observed in the temporal parafoveal region, reflecting photoreceptor damage. Thinning of the neurosensory retina and loss of normal foveal contour become evident. In the neovascular stage, OCT reveals subretinal hyperreflective material consistent with choroidal neovascularization, frequently accompanied by subretinal fluid, intraretinal cystic changes, and focal retinal thickening.
On optical coherence tomography angiography (OCTA), the superficial capillary plexus typically shows mild capillary rarefaction with dilated and right-angled venules, predominantly in the temporal parafoveal region.
The deep capillary plexus demonstrates more pronounced abnormalities, including telangiectatic and ectatic vessels, capillary dropout, and disorganization of the vascular network, which represent the hallmark vascular changes of MacTel type 2.
In the avascular (outer retinal) slab, the presence of a pathologic flow signal indicates subretinal neovascularization, appearing as a tangled, irregular vascular complex extending from the deep plexus into the outer retina. This neovascular network is often better delineated on OCTA than on conventional angiography and correlates with exudative changes observed on structural OCT.
The patient’s imaging findings after three doses of anti-VEGF therapy are shown below. Visual acuity impoves after treatment to 0.5/0.4.Crystalline deposits are more prominent on color photography of the right eye after anti-VEGF treatment.

After the patient is treated with anti-VEGF injection, disorganization or intraretinal fluid and subretinal exudative fluid findings are resolved and the patient’s acuity returns to baseline.
Macular telangiectasia type 2 (MacTel type 2) is a bilateral, neurodegenerative retinal disorder characterized by parafoveal capillary abnormalities and progressive retinal structural changes, which may be complicated by secondary subretinal neovascularization in advanced stages. In the neovascular form, multimodal imaging reveals distinct and complementary findings. Fundus examination may show parafoveal graying, right-angled venules, crystalline deposits, and signs of subretinal neovascular tissue or hemorrhage. Fundus autofluorescence typically demonstrates increased parafoveal autofluorescence, reflecting macular pigment depletion, with superimposed areas of reduced autofluorescence corresponding to neovascular scarring or hemorrhage. Spectral-domain OCT shows inner and outer retinal cavitations, disruption of the ellipsoid zone, retinal thinning, and in neovascular cases, hyperreflective subretinal material associated with subretinal or intraretinal fluid. OCT angiography plays a pivotal role by revealing telangiectatic vascular changes in the superficial and deep capillary plexuses, with neovascular networks often originating from the deep plexus and extending into the outer retinal and avascular slabs. Together, these imaging features support the diagnosis, help differentiate MacTel type 2 from other macular neovascular entities, and guide monitoring and treatment response following anti-VEGF therapy.
Credit: M. Giray Ersoz, MD, FEBO, Retina Specialist
Memorial Bahçelievler Hospital, Department of Ophthalmology, Istanbul, Turkey
Arel University School of Medicine, Department of Ophthalmology, Istanbul, Turkey
Instagram accounts: @retina.review and @retina.dr.girayersoz
Website: www.girayersoz.com.tr
and Sepideh Lotfi, MD
Biruni University School of Medicine, Department of Ophthalmology, Istanbul, Turkey
Instagram accounts: @sepidls

